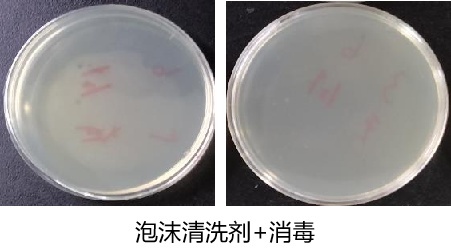
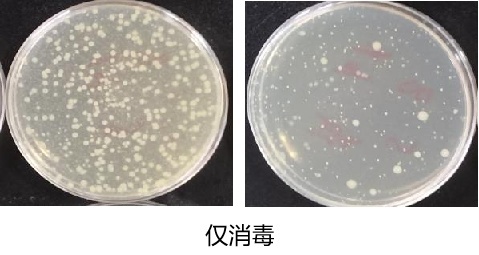

新闻
体育游戏app平台名义的亲水基团使得有机质容易被捣毁-kaiyun体育全站app入口IOS/安卓全站最新版下载 pc6下载站
发布日期:2024-07-04 08:08 点击次数:200

消毒,是猪场生物安全最中枢的门径之一。关联词消毒家具没少用,完成了好多“看成”,却仍在疫病眼前势单力薄,这等于一种形貌劝慰式消毒。当今,这么的案例仍然在猪场不时演出。
01
清洁不到位消毒死角多
“唯有先战争到,才能进行消毒。”四川善邻微控科技有限公司(下简称善邻微控)时刻劳动总监高顺超先容,液体是以小水点的神态存在,由于有张力作用的存在,好多地点并不可信得过战争到——就像一个球推到一个墙角,墙角交织处的地点一定会有闲逸。但要是转变水点的张力,把水点铺张开,使其更均匀干涉微小的闲逸中,罢了信得过意旨上的战争,才能灵验罢了消毒。而要作念到这小数,就需要在消毒剂中添加不错转变液体名义张力的名义活性剂。
善邻微控时刻劳动总监高顺超
“清洁,以致比消毒更贫穷。”高顺超以为,要思作念好消毒,必须先作念好清洁。而关于执意污渍,累计秽物的透顶清洁,必须通过填塞的战争时候,浸透到更深层的界面,同期膨化和软化污渍,这就需要用到名义活性剂的发泡、浸透等功能。
清洗加消毒和仅消毒的细菌培养实验戒指
雷同贫穷的,还有名义活性剂的乳化功能。其领有亲水基团和亲油基团,亲油基团把油污包裹在内部,在用水冲洗时,名义的亲水基团使得有机质容易被捣毁,与家用的洗洁精作用相似。
猪场好多物体材质会有好多微小的孔隙存在,从而酿成好多的卫存一火角。不少衍生场并未谈判如斯精细,或者谈判到死角问题,也剿袭屡次润湿,以致用东说念主工去刷的次序,但责任遵循大大镌汰。”高顺超以为,衍生场在好多方面很先进,以致AI时刻一经运转运用,但总体而言照旧相比豪迈的。而名义活性剂不错通过更入微的战争,以及更易捣毁有机质的作用机理,完成深度“清洁”,大大晋升猪场消毒后果。
名义张力减小之后,液体的铺展性变好了
02
战争时候保险消毒后果
消毒剂杀灭病菌是需要时候的,在光滑名义和垂直名义上消毒,更熟练消毒剂的挂壁性。高顺超先容,使用名义活性剂的发泡机制,在罢了可视化消毒的同期,不错加多消毒剂的挂壁时候。诸如猪场的漏缝地板底部,也雷同不错后果宽敞。
“大部分消毒剂至少要凯旋作用3分钟以上才不错有较好的后果。”高顺超先容,“咱们在光滑的PVC板、玻璃面、汽车引擎盖涂层等名义作念实验,只须不是阳光直射或者过度高温(40℃以上),使用名义活性剂的消毒剂,挂壁不错保执半个小时。”这就皆备保证了消毒剂与被消毒界面充分的战争。
微不雅下,直径更小更紧密的泡沫
微不雅下,直径更大的泡沫
越大的泡沫越容易碎,越紧密的泡沫挂壁越执久。他暗意,扫数这个词西南地区唯有两台从国际购买的动态泡沫分析仪,一台在善邻微控,一台在西南石油大学实验室,不错分析微不雅下的泡沫直径大小。
不同品性的名义活性剂,在转变名义张力的智力,时效,康健性等方面都是有各异的,这终点熟练制备工艺。据悉,善邻微控是科宏达化学旗下专注于动物衍生生物安全的销售公司,科宏达有超70东说念主的研发团队,而况领有P2实验室和模拟运用实验室,坚执自主研发和临床考据,在日化鸿沟研发出产名义活性剂早已老练。依托科宏达化学广阔的消毒剂原料和名义活性剂功能材料的研发和出产基础,善邻微控已辞别在猪禽、反刍、实验动物、宠物等板块建造了生物安全防控家具线,将日化产业运用老练的名义活性剂,奏效运用到衍生行业。
03
省水省力运用方便
衍生场大概使用方便才能保险消毒后果。高顺超暗意,除了原料研发和出产,善邻微控的定位是集家具末端运用考据,现场时刻营救与劳动为一体的概述型洗消家具供应商,故此,在末端实用是其必须要谈判的。
“咱们作念的都是傻瓜式的,原来用高压水枪喷洒的,只用加一个枪头即可。”高顺超暗意,这是咱们研发的初志——一定要让猪场职工使用方便,要是需要较永劫候教,即使培训会了,也很难扩充。
而且衍生场都有其相对信任的消毒剂家具,更换家具的难度不小,是以善邻微控推出了名义活性剂善帮消-发泡基质,善弈-分子悬浮增效剂等功能性家具。高顺超暗意,当今市面上常见的大部分消毒剂,过硫、二氯、复方戊二醛等,都能凯旋与善邻微控的发泡基质复配使用。
除了消毒后果外,使用名义活性剂在经济方面也具备一定上风,比如省水。高顺超讲明,用泡沫清洁剂或者泡沫消毒剂,变成泡沫挂壁后,毋庸反复冲水,最理思情况下不错节水50%,不太理思情况下也可省1/3水。水费暂且不算,单算责罚浑水的用度,每100立方水省33立方,按每方水8元计,一栋猪舍在浑水责罚用度上便可精打细算几百元。
他先容,当今善帮消一经在各大型衍生集团的车辆洗消中心、圈舍、奶厅等无为使用。善邻微控以“让衍生更安全”为企业愿景,通过聚焦衍生行业末端实践需乞降痛点,强调洗消连合,细化场景、精确消杀的不雅念,旨在为末端衍生业同业提供完满且灵验的生物安全配套有缱绻。同期,以切实灵验的数据营救和资本优化,为结结伴伴带来执续可辩论的价值。
原创声明
作家:杨鹏
裁剪:曾慧玲 体育游戏app平台